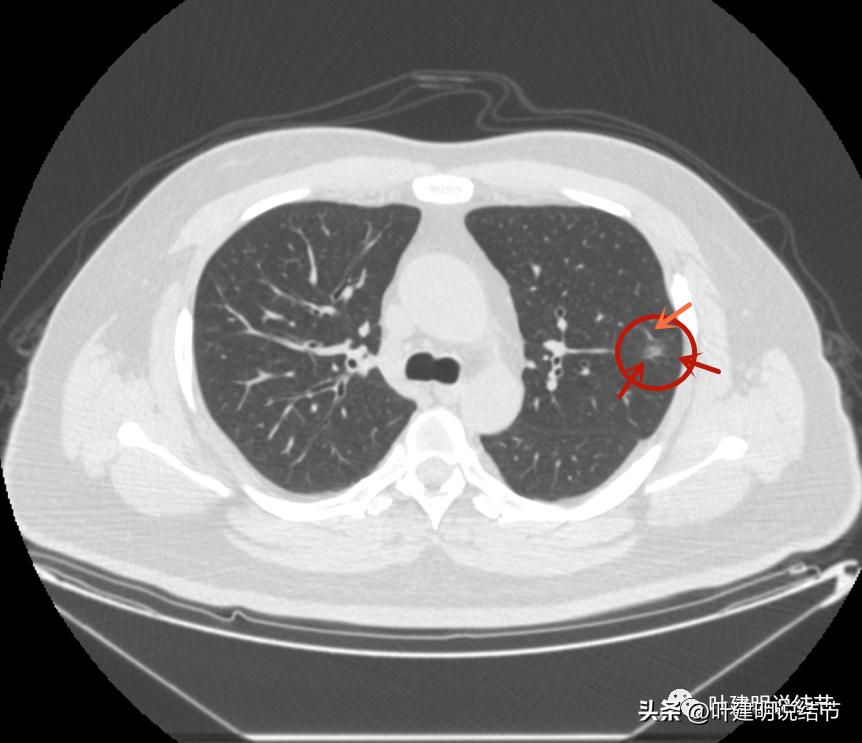
如何判断肺磨玻璃结节是高危结节,肺上有混合磨玻璃结节要注意什么
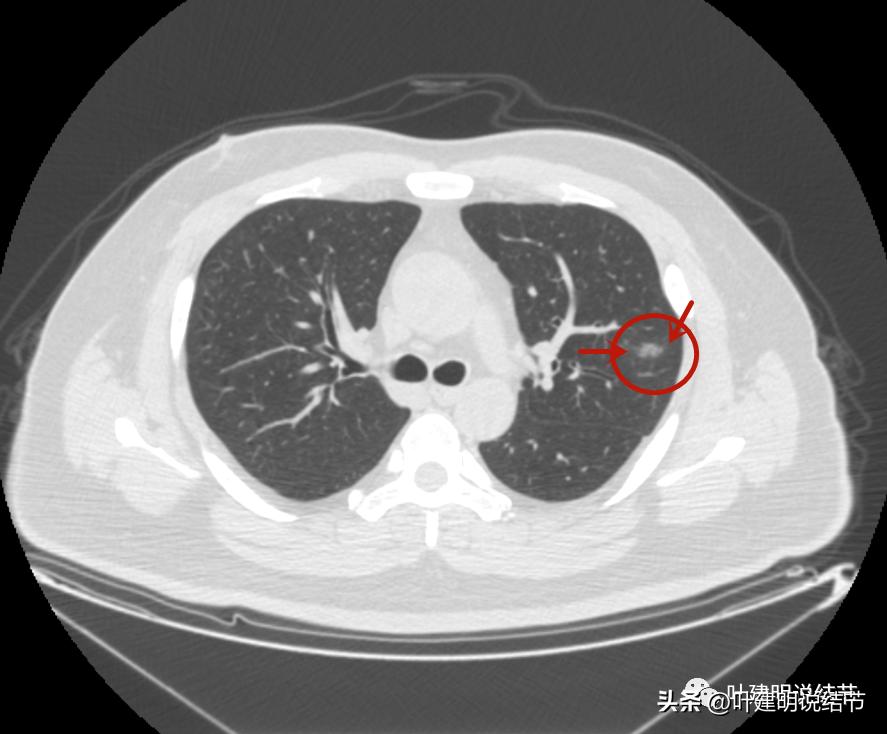
如何判断肺磨玻璃结节是高危结节,肺上有混合磨玻璃结节要注意什么
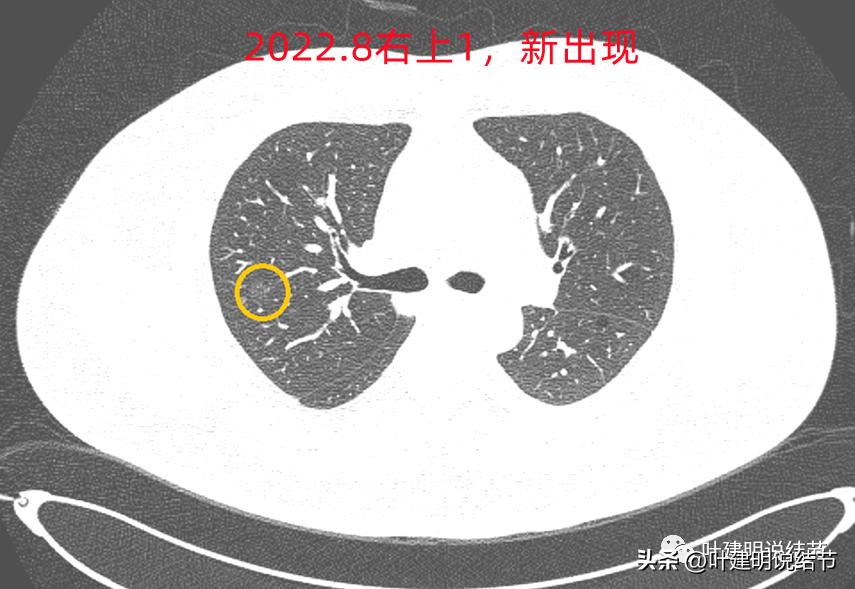
如何判断肺磨玻璃结节是高危结节,肺上有混合磨玻璃结节要注意什么

网络咨询病例:

前几天有位同事联系我,说她在省外的有位朋友查出来有肺结节,得知我入职浙江大学医学院附属杭州市肿瘤医院了,一定要叫她帮忙联系,让我看看其胸部CT片,或者约个时间来杭州看。但我告诉同事,现在微信这么方便、影像资料的传输如此便捷,根本不必亲自来杭州,建议将影像资料发给同事,再转发给我看就可以了,如果没有电子版的图像资料,可以到检查的医院去拷贝的,打包发我邮箱就可以,以免舟车劳顿之苦。次日,我拿到了其影像资料。一般我是先看最近的CT,对病灶的良性或恶性有初步的判断,再找最早的对比,看有没有变化,得出最终的判断结果。但这位结友因为发现已经2年多了,所以我是先看2020年1月的。我们先来看其当时的片子:

左上病灶1:磨玻璃结节,轮廓清楚伴微血管进入,中间似乎有空泡征,感觉像原位癌或不典型增生;

左上病灶2:混合磨玻璃结节,密度偏高,边缘稍糊,但轮廓相对清,有微血管分支进入,考虑微浸润性腺癌或浸润性腺癌可能大;

左上病灶3:混合磨玻璃结节偏实性,内部密度不均,整体轮廓清,有浅分叶,也有小血管关系密切,考虑浸润性腺癌可能性大;

左上病灶4:舌段磨玻璃结节,边缘显力糊,整体轮廓较清,不典型增生可能性大点。
我看后的第一个感觉是,怎么这么明显像恶性的结节,还没有开刀呢?现在2年多过去了,不知道进展到如何,还有没有手术机会?第二个感觉是这个多个病灶集中在左上叶,其他肺上不明显,感觉有点怪怪的,多原发癌一般不同叶的更常见些。我想先再看看细节信息,所以又逐幅图再仔细看了一遍:
左上病灶1:



连续层面看,仍是像恶性范畴的,总体密度低,轮廓清,原来判断腺体前驱病变的意见不变。
左上病灶2与左上病灶3:

病灶2出现,还只有一点点磨玻璃影,血管走行有点异样
密度略显高,有微血管进入(桔色箭头),边缘略模糊,但轮廓还是较清

中间有实性成分出现(粉色箭头),微血管进入明显(桔色箭头),边上有磨玻璃成分(绿色箭头),整体轮廓清

病灶密度不均

密度不均显杂乱

表面略不平
整体瘤肺边界与轮廓较清

边上另有病灶出现,即左上病灶3(蓝色箭头)

病灶3也有微血管进入(桔色箭头)

病灶3密度不均,轮廓清,有细毛刺样征(紫色箭头)

瘤现边界清

边上似乎有斑点状(绿色箭头),是不是卫星灶?

似乎有偏实性成分出现,密度较为杂乱

密度不均,瘤肺边界清,似乎是乱石征的影像

有偏实性成分,表面不平,边缘似乎有磨玻璃密度的成分

毛刺征(紫色箭头),微血管征(桔色箭头),实性点状成分(粉色箭头),整体轮廓较清(红色箭头)

血管弯征(桔色箭头)

血管进入

病灶3边缘部分的样子
感觉这两个病灶也是较为典型的恶性结节,但略不确定的是有的层面似乎有点像有卫星灶,再有就仍是这么多病灶集中在相对较小的区域内有点难以理解。
左上病灶4:

病灶出现,是淡磨玻璃影,但有微血管进入(桔色箭头)

密度稍不均,中间点状偏高密度,是不是血管?

周围微小血管好像有往病灶集中的趋势(桔色箭头)

病灶有胸膜间隙征(黄色箭头)、细毛刺样征(紫色箭头),整体轮廓较清(红色箭头)

轮廓清而密度稍不均,但总体仍应该算纯磨玻璃密度

有明显的血管穿行与细毛刺征
这个病灶也仍考虑是恶性范畴的,只是风险较病灶2与病灶3为低。也就是说看了细节与所有层面的信息,仍基本上认为四个病灶都是肿瘤范畴的,病灶1与病灶4大概浸润前病变可能性大,病灶2与病灶3则至少微浸润,基本以浸润性腺癌可能性大,不过不太能理解的有两点:一是病灶太集中;二是有的层面似有卫星灶。当然病灶2与病灶3感觉磨玻璃的成分偏少了些,也可作为疑惑之处。
后续再看2022年8月的CT图像,有点惊掉下巴的感觉:



左上叶的病灶1、2、3都没有了!!!完全没有了!那当然说明是炎症性的,居然全部吸收了!

但左上病灶4仍在,形态也没有明显变化,无好转,也无明显进展。这是肿瘤性质的吗?虽然存在2年多了,但因为它的兄弟们都不见了,让我对它认定的肿瘤范畴也产生了怀疑,也许是纤维增生而已呢!
右上叶倒又出现了新的病灶:
右上病灶1:是新出现的,密度甚低,但轮廓较清,不典型增生吗?

右上病灶2:新出现的,整体轮廓较清,但感觉较散在,不致密,也不是圆形或类圆形,大概是炎性的吧!
2020年时同样位置是没有异常的:


还敢判定右上的病灶是恶性范围的不典型增生或原位癌吗?我是连左上病灶4都不敢了!还好,我觉得我们不必去纠结这几个病灶到底是不是肺癌或腺体前驱病变,反正至少风险很低,能随访就是了,肯定不能建议手术或消融等干预,也不需要穿刺活检。只要仍继续随访,半年吧!将结果交给时间来判断。
感悟:
这个病例给了我许多感想。我想也许对我们所有专注肺结节的病友或医生都有一定的警示或提醒作用,我认为提示我们:1、混合磨玻璃结节并不总是恶性,当其为炎症恢复期的时候,与肿瘤有时很难区分,也是轮廓较清,密度不均杂乱,甚至有血管征。但要注意一是有没有临床症状;二是多发时区域集中在较小范围否;三是磨玻璃成分较少或不太明显而偏实性的成分更多。但它们的收缩力一般是弱的,因为是炎症嘛;2、检查发现的肺结节,不管纯磨还是混合磨玻璃,即使我们认为是典型的恶性,仍不能过于积极马上建议手术切除,给机体一点时间,也给患者一个机会,万一是炎症呢,过些天告诉病人“是炎症,不需手术了”,避免一次不必要的手术远比先手术,术后说“恭喜你,是良性的”更加动听;3、影像的特征,判断都是相对的,远没有百分这百,时间永远是大师,它不会错;4、磨玻璃结节决定手术前,即使不久前查过CT,最好仍再复查一次。因为我之前碰到过有的几年了持续在,而且半个月前复查也在的,术前定位时扫描发现不见了的;也有几年复查都在,但因变化不明显,继续随访,再后一年复查缩小或消失了的。门诊甚至碰到头一天在内科门诊检查发现很明显的混合磨玻璃结节,瘤肺边界与轮廓都清,考虑浸润性腺癌,次日到我门诊来,我申请再查下靶扫描,居然吸收得干干净净的,真的只有一个晚上,就无影无踪的了。5、还是我一直坚持的观点,是否手术干预,要以风险大小来衡量,不要纠结最后是什么,即使考虑恶性可能性大,当风险还不大的时候,可以再观察下,复查一次再定。真是危险性很高的,即使不是百分之百确定为恶性,也宜干预处理,以绝后患。


(此处已添加医疗卡片,请到*今条头日**客户端查看)